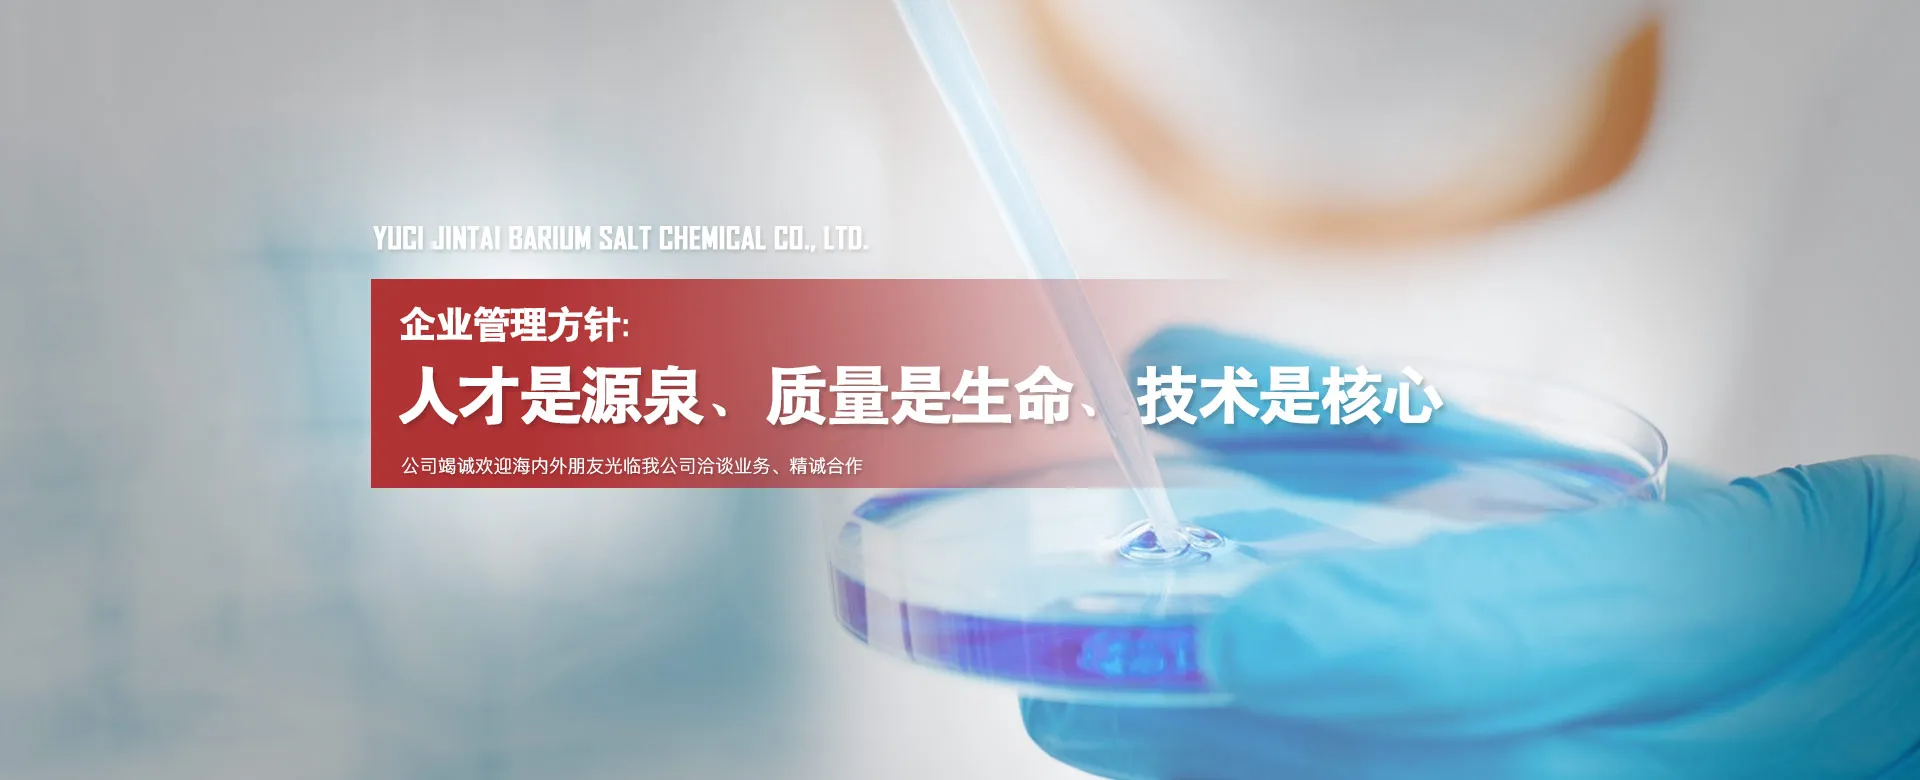

榆次金泰钡盐化工有限公司
榆次金泰钡盐化工有限公司
主营产品:
八水氢氧化钡 / 一水氢氧化钡 / 偏硼酸钡
认证的制造型企业
企业类型
生产型工厂
员工总数
100-500人
厂区面积
74
亩
年度总营收
4000 万
成立年限
53+
关于我们
榆次金泰钡盐化工有限公司
榆次金泰钡盐化工有限公司(原名榆次市建筑材料厂)始建于1971年,于2003年3月改制为榆次金泰钡盐化工有限公司。位于山西省晋中市山西示范区晋中开发区潇河产业园区兴隆路东侧。西距南同蒲铁路1.5km,108国道3km。交通极为便利。公司占地面积49087平方米,现有职工110人。
我公司拥有先进的生产技术;完善的检测仪器;科学的管理方式;娴熟的生产工人。1993年开始生产氢氧化钡产品至今。现生产的“榆贝”牌八水氢氧化钡、晶体一水氢氧化钡、偏硼酸钡等产品,远销美国、欧洲、日本、东南亚、南非、台湾等国家和地区。年产量10000吨。年销售收入4000万元。其中氢氧化钡系列产品获“山西省优质产品”称号。在“99国际化学科技技术成果博览会暨产品推广研讨会”上荣获金杯。2002年被山西省经济贸易委员会授予“山西省科技型中小企业”并率先通过IS09001:2000国际质量管理体系认证。连续十多年来获得晋中市工商局授予的“重合同守信用企业”称号。2009年6月被山西省科技厅认定为“山西省民营科技企业”。2010年被晋中市榆次区人民政府评为“全区环境保护先进企业”。
我公司主要产品有八水氢氧化钡、 晶体一水氢氧化钡、 偏硼酸钡等,经过我公司精制的产品可达无氯、无钠、低锶、极低铁。
公司竭诚欢迎海内外朋友光临我公司洽谈业务、精诚合作、共谋发展、再铸辉煌。
查看详情

公司介绍
最近的出口港
天津港
最近国际机场
太原武宿国际机场
最近的核心城市
北京
离核心城市距离
408KM



公司证书
| 质量认证 | ISO9001(中文) ISO9001(英文) |